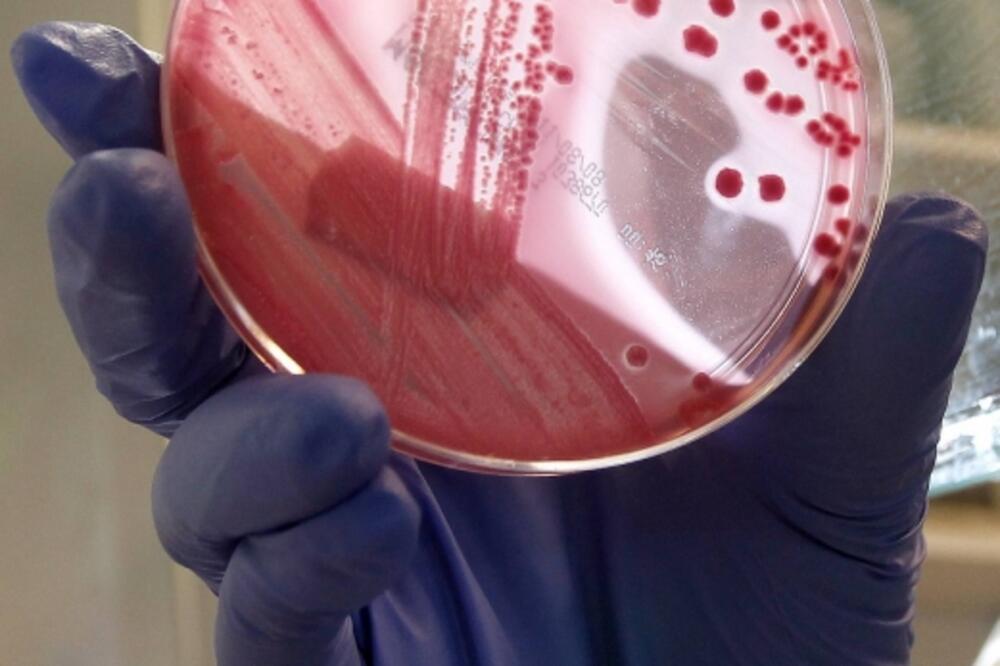
ešerihija koli, Foto: Beta

Krastavac iz Španije, za koji se do sumnjalo da je izazvao epidemiju entero-hemoragijske ešerihije koli (EHEC) u Njemačkoj, u posljednjih mjesec dana nije uvožen u Crnu Goru, saopštili su iz Sanitarne inspekcije.
“Povrće koje se nalazi na tržištu Crne Gore najčešće je porijeklom iz Makedonije, Turske i Srbije”, piše u saopštenju.
Hamburška ministarska zdravlja Kornelija Prifer-Štorks, saopštila je da krastavac nije uzrok brzog širenja zaraze na sjeveru Njemačke. Time je njemačkim zdravstvenim vlastima ponovo u potpunosti nepoznat pravi izvor zaraze.
Stručnjaci još nijesu utvrdili koje su namirnice dovele do izbijanja zaraze i njenog brzog širenja, iako su istraživanja pokazala da su krastavci uvezeni iz Španije bili zagađeni opasnom crvenom bakterijom. Za njih je još nejasno zašto je pretežna većina oboljelih u velikim gradovima na sjeveru zemlje, i zašto su 70 odsto zaraženih žene.
U Crnoj Gori, prema podacima Instituta za javno zdravlje, do sada nije registrovan slučaj obolijevanja uzrokovanih enterohemoragijskim sojevima ešerihije koli.
Sanitarna inspekcija je, zbog aktuelne epidemiološke situacije, pojačala nadzor nad povrćem koje se uvozi i stavlja u promet na tržištu Crne Gore.
“U zavisnosti od razvoja epidemiološke situacije u regionu i na osnovu preporuka Svjetske zdravstvene organizacije, Sanitarna inspekcija i Ministarstvo zdravlja će predizimati dalje mjere”, saopštili su iz te inspekcije.
Oni su objasnili da se povrće kontroliše prilikom uvoza i u unutrašnjem prometu, ali i po prijavi građana.
“Nadzor podrazumijeva fizički pregled, pregled dokumentacije koja se prilaže uz svaku pojedinačnu pošiljku i uzimanje uzoraka. Inspektor vrši uzorkovanje na osnovu sopstvene procjene rizika, zasnovane na prethodno izvršenom fizičkom pregledu, pregledu ambalaže i prevoznog sredstva, informacija o neispravnosti u drugim zemljama, informacija iz medija”, objasnili su.
Sve više zaraženih
U Njemačkoj gdje se prvi put pojavila zaraza prije desetak dana, umrlo je 15 osoba, a oboljelo 1.400 od bakterije ešerihija koli, prenosi BETA. Najveći broj zaraženih je na sjeveru te zemlje, a pored nje ugrožena je i Švedska. U toj državi je registrovano 39 slučajeva zaraze. Kako javljaju agencije, juče je preminula 50-godišnja žena, dok, prema pisanjima medija, broj oboljelih raste.
U Danskoj je registrovano 11, u Velikoj Britaniji tri oboljela, a prvi slučaj zabilježen i u Češkoj.
Do sada nije tačno utvrđen izvor zaraze bakterijom ešerihija koli, a vlasi na sjeveru Njemačke preporučile su stanovništvu da ne jede krastavce, zelenu salatu i paradajz. Ipak, njemački eksperti ocijenjuju da će broj inficiranih da raste bez obzira na preporuke o higijeni prilikom pripreme hrane i izbjegavanju svježeg povrća.
SZO je opisala zarazu kao veliku i tešku. i pozvala evropske države da rade zajedno na rješenju problema.
Pogledajte još:
Preuzmi aplikaciju i prati vijesti
PRATITE NAS NA